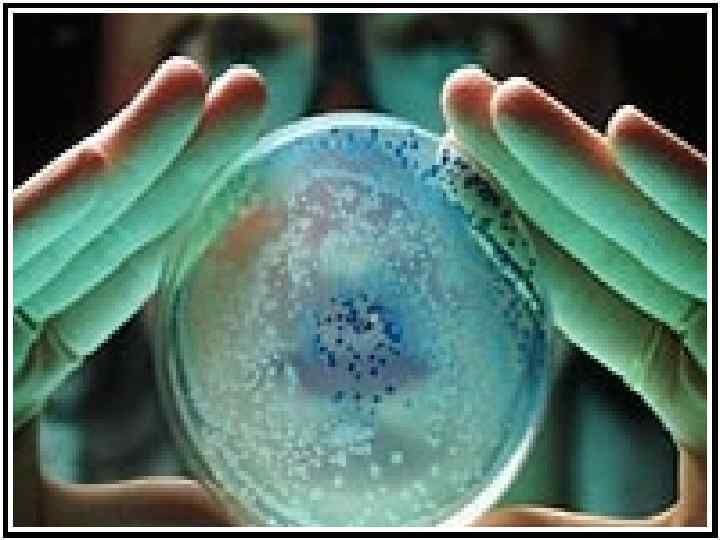

Персистирующая инфекция – это заболевание, которое вызывается бактериями, обитающими в человеческом организме. Некоторые из них не представляют угрозы для здоровья, но другие – несут постоянную угрозу, а потому защитные механизмы организма тщательно контролируют их размножение. Длительное пребывание таких «спящих» агентов – это и есть причина болезни.
Что это за инфекции?
Обращаясь к медицинской терминологии, персистенция – это способность микроорганизмов, которые вызывают инфекцию, долго прибывать в организме человека без проявления клинических симптомов. При этом они способны при определенных условиях к активации, что провоцирует развитие инфекционного заболевания.
Механизм, который запускает развитие или активацию персистирующей инфекции, напрямую зависит от состояния здоровья человека – от того, насколько его организм силен, чтобы блокировать скрытую инфекцию.
Персистирующая инфекция может иметь латентную форму, что означает бессимптомное протекание инфекции, не сопровождающаяся выделением во внешнюю среду. При латентной форме инфекцию или вирус не удается обнаружить с помощью привычных диагностических мер, которые применяются в медицине.
Под влиянием внешних факторов, персистирующая инфекция может выходить и проявляться клинически. К таким факторам можно отнести:
- снижение иммунитета (дополнительно читайте, );
- сильный стресс;
- переохлаждение;
- снижение защитных функций организма на фоне другого заболевания.
Медицинская сфера на данный момент не до конца изучила такое явление, как персистирующая инфекция, а потому, при латентной форме заболевания пациент считается здоровым, терапия для лечения не применяется. Но, несмотря на то, что нет проявлений острой инфекции, не учитывается прогрессирующий хронический процесс, который вызван нахождением антигенов (скрытой инфекции) в организме человека, а это может спровоцировать соматическую патологию.
Возбудители инфекции
Не все микроорганизмы способны существовать в организме человека и при этом «не выдавать себя». Вирусы, которые могут персистировать, обязательно должны обладать таким свойством, как внутриклеточное существование в микроорганизме. В число таких агентов входят:
- хламидии;
- микоплазмы;
- хеликобактер;
- вирусы группы герпесвируса;
- гепатит;
- токсоплазмы.
Перечисленные вирусы, несмотря на свое существование в организме человека, стремятся к тому, чтобы иммунная система организма не смогла их распознать. Это происходит за счет того, что вирусы интегрируются с геномом человека, а потому, инфекционный процесс развивается медленно и может остаться без внимания.
Хроническая персистирующая инфекция может поражать любые клетки организма и проявиться только в случае, если человек уже перенес инфекцию ранее. В организме возбудитель инфекции остается в латентной форме и обостряется тогда, когда у человека снижаются защитные функции организма.
В группе риска хронической персистирующей инфекции находятся следующие лица:
- доноры крови;
- недоношенные дети;
- беременные;
- онкобольные;
- медицинский персонал;
- пациенты с иммунодефицитом.
Хроническая персистирующая инфекция может протекать в легкой, средней и тяжелой форме (при тяжелой форме возможен даже летальный исход). Поскольку при такой инфекции могут поражаться разные системы и органы организма, проявляться она может общей слабостью организма, мышечными болями, жаром, увеличением лимфоузлов, гепатитом, желудочно-кишечными патологиями.
Течение острых инфекций отличается от течения инфекционных процессов, которые вызывают персистирующие вирусы. Например, если острая инфекция (грипп, корь и т. д.) проявляет себя сразу же, то персистирующие инфекции протекают хронически с возможными вспышками паталогических процессов. Так, у персистирующих инфекций есть две формы – латентная (ремиссия) и обостренная (когда вирус активируется).
Воспалительный процесс, который вызывает персистирующая инфекция, приводит к изменениям во всех системах организма: морфологическим, метаболическим, структурным. Это отражается на органах и их работе.
В латентной форме распознать скрытую инфекцию самостоятельно невозможно, так как нет никаких признаков, которые указывали бы на нее. В таких случаях затрудняется даже диагностика. А вот хроническая персистирующая инфекция подает некоторые сигналы. Всё зависит от того, где именно локализовался очаг воспаления. Например, при поражении органов мочеполовой системы пациенты жалуются на такие проявления:
- болезненное мочеиспускание;
- учащенное мочеиспускание;
- мутный цвет мочи или же наличие в ней кровяных сгустков или гноя.
К другим признакам хронической персистирующей инфекции, которые не затрагивают мочеполовую систему, относят:
- озноб;
- лихорадку;
- слабость и боль в мышцах (вплоть до полной невозможности встать с постели);
- увеличение селезенки;
- спутанность сознания.
Важно понимать, что по таким признакам сложно поставить точный диагноз, а саму скрытую инфекцию можно и вовсе упустить из виду.
Диагностика и лечение
Только лабораторные исследования могут подтвердить наличие или отсутствие хронической персистирующей инфекции. Это:
- цистоскопическое исследование биологического материала (соскоб из уретры, исследования мочи и слюны) – позволяет обнаружить характерные клетки персистирующего вируса;
- молекулярно-биологическая диагностика – помогает выявить вирусный ДНК геном;
- иммуноферментный анализ – помогает обнаружить специфические антитела.
При обнаружении персистирующей инфекции перед врачами стоит сложная задача, так как данная патология лечится с трудом. Как правило, лечение проводится комплексно и включает в себя два аспекта:
- Терапию противовирусными препаратами (Фоскарнет, Ганцикловир).
- Терапия иммунными средствами. Она нужна потому, что часто персистирующая инфекция переходит в острую форму на фоне иммунодефицита.
Каждый курс лечения подбирается индивидуально и только лечащим врачом.
Персистирующая инфекция – очень сложная патология, которая у каждого пациента протекает индивидуально, поэтому важен такой подход в лечении, который основан на состоянии здоровья пациента и его общей истории болезни.
Особенности инфекции у детей
Поскольку детский организм слаб и окончательно крепнет только в период подросткового созревания, он очень уязвим для развития персистирующей инфекции. Особенно подвержены вирусным болезням новорожденные и дети в возрасте до 10 лет.
Дети могут «подхватить» персистирующую инфекцию двумя способами:
- от другого больного человека или животного, при контакте с инфекционной средой;
- из внешней среды, так как детский организм никак не препятствует вирусу, который свободно входит в благоприятную среду и там размножается.
Если в детский организм проникает более двух возбудителей, то возникает инфекционная болезнь, которая дает о себе знать (и только после перенесенной болезни вирус может остаться в организме в латентной форме).
Выявить вирусное заболевание можно по следующим признакам:
- жар (температура от 38 до 40 градусов);
- непрекращающаяся головная боль;
- вялость;
- отсутствие аппетита;
- сильное потоотделение;
- боль в мышцах;
- тошнота и рвота.
Дополнительно к этим симптомам могут проявиться и осложнения. Как правило, они возникают, если вовремя не обратиться к врачу, и выглядят следующим образом:
- лихорадка;
- охриплость или полная потеря голоса;
- кашель;
- заложенность носа и выделение гноя из пазух.
В домашних условиях можно оказать малышу первую помощь (до постановки точного диагноза и назначения лечения):
- придерживаться меню, обогащенного фруктами, овощами и молочными продуктами;
- постараться сбить температуру – малышам до года можно поставить свечку, а малышам старше года можно дать Ибупрофен для детей.
Персистенция От лат. persisto — постоянно пребывать, оставаться, длительное существование, присутствие длительное пребывание инфекта в организме животных и человека либо без клинических патологических проявлений (латентное течение, ремиссия инфекционного процесса), либо способных при определенных условиях (иммунный дисбаланс и иммунная недостаточность различной этиологии — стресс, переохлаждение, интеркуррентная инфекция, обстрение хронического заболевания и т. д.) к активации с исходом в заболевание (активное течение, обострение инфекционного процесса).
Механизмы персистенции: — Образование L-форм Антигенная мимикрия Иммуноглобулиновый покров Способность секретировать вещества, препятствующие действию иммунных факторов Сорбция белков хозяина на поверхности клетки и экранирование от иммунной системы хозяина Антифагоцитарные факторы: Капсулы Микрокапсулы Слизистые чехлы Вещества снижающие хемотаксис Незавершенный фагоцитоз и др
Действие бактерий на цитокины: Действие Разрушают цитокины Бактерии Н. aeruginosa с помощью ферментов L. pneumophila Связывают цитокины Е. coli Подавляют синтез Цитокинов Цитокины ИЛ-2, ФНОа, ИФ-у ИЛ-2 ИЛ-1, ИЛ-2, ФНОа, ГМКСФ S. typhimurium, S. flexneri ФНОа M. tuberculosis ТРФ(3 M. avium ИЛ-6 L. monocytogenes ИЛ-3, КСФ-1 E. coli ИЛ-2, ИЛ-4, ИЛ-5, ИФ-у Y. enterocolitica, B. suis, V. ФНОа cholerae, B. anthracis P. aeruginosa ФНОа, ИЛ-1, ИФ-у S. typhimurium ИЛ-2
Антилизоцимная и антилактоферриновая активность: Микроорганизмы n Антилактоферриновая активность, Антилизоцимная нг/мл активность, мкг/мл M ± SD S. aureus S. haemolyticus S. epidermidis E. coli Klebsiella spp. 15 22, 72 ± 1, 88 10, 1 ± 2, 17* 16 20, 08 ± 1, 41 4, 40 ± 1, 12 15 11, 50 ± 1, 45* 9, 91 ± 0, 82* 16 22, 84 ± 1, 41 4, 19 ± 0, 61 12 7, 83 ± 1, 13* 8, 92 ± 2, 45* 15 5, 65 ± 0, 62 1, 24 ± 0, 25 12 23, 87 ± 0, 67* 2, 58 ± 0, 27* 12 18, 17 ± 3, 20 1, 64 ± 0, 15 12 19, 40 ± 2, 47 3, 24 ± 0, 27* 14 18, 13 ± 0, 64 1, 83 ± 0, 28 Больные ревматическими заболеваниями Контроль *Статистически достоверно
Образование L-формы — бактерии, частично или полностью лишённые клеточной стенки, но сохранившие способность к развитию. К возникновению L- форм приводит воздействие агентов, блокирующих выработку клеточной стенки: 1. антибиотики (пенициллины циклосерин, цефалоспорины, ванкомицин), 2. ферменты (лизоцим, амидаза, эндопептидаза), 3. ультрафиолетовые и рентгеновские лучи, 4. аминокислота глицин.
История вопроса: Буква L — первая буква названия Листеровского института в Лондоне, где впервые доктор наук Эмми Кляйнебергер-Нобель в 1935 году обратила внимание на развитие морфологически весьма необычных клеток в культуре бактерий Streptobacillus moniliformis, выделенной из жидкости уха крысы.
вакуоли L-форма Bacillus subtilis, масштаб — 500 нм. Многообразие L-форм Bacillus subtilis, при масштабе в 10 мкм.
L-формы Особенности L- форм: 1. Синтез полноценной клеточной стенки невозможен Возвращение в вегетативную форму при нормализации факторов окружающей среды Возвращение в вегетативную форму невозможно. Дальнейшее существование как у микоплазм Сходные культуральные свойства. 3. Постепенное превращение из грамположительных в грамотрицательные структуры. Образование стабильных и нестабильных Lформ. 5. Изменение антигенных свойств (утрата К- и Оантигенов). Приобретение способности к персистенции. 6. Снижение вирулентности в связи с утратой различных факторов патогенности (адгезии, инвазии, эндотоксина и т. п) стабильные Система генетического контроля синтеза клеточной стенки (пептидогликан) 2. 4. нестабильные Сходство морфологических изменений: образование нитевидных, волокнистых, колбасовидных, шаровидных и гранулярных форм.
Механизм фагоцитоза: Хемостаксис Силы физико-химического взаимодействия Градиент концентрации 2. Стадия адгезии Осонизация (АТ, С 3 b, фибронектин, сурфактан) Физико-химическое взаимодействие 3. Эндоцитоз 4. Микробоцидность Кислороднезависимая кислородзависимая
макроорганизм 1. Нарушение слияния фагосомы с лизосомой (микобактерии туберкулеза, простейшие, токсоплазмы) 2. Резистентность к лизосомальным ферментам (гонококки, стрептококки гр А, микобактерии, ерсинии) 3. Длительная персистенция в цитоплазме (хламидии, риккетсии) микроорганизм
Механизм персистенции хламидий Типичные включения, содержащие элементарные и ретикулярные тельца 48 часов после инкубации Патоморфологическая модель персистенции. После перенесенного теплового шока во Включениях меньших размеров содержатся крупные патологические формы хламидий
Макрофаг не презентирует основной АГ (MOMP) Экспрессия ранних Генных продуктов лизосома Антигенная перегрузка Гиперпродукция Ig A, G ГЗТ Антигенная мимикрия Сфингомиелинсодержащие экзоцитозные пузырьки, КГ hps 60 — белки теплового шока Липополисахарид. Не экспрессируется Состояние между Ретикулярными и Элементарными тельцами MOMP- не экспрессируется
+ Антифагоцитарная активность: 1. Плотная клеточная стенка элементарных телец (дисульфидные связи между структурами белка MOMP) 2. Прочность ретикулярных телец (полисахаридная капсула) «несостоятельность» Респираторного взрыва Активация СПОЛ и повреждение Мембран собственных клеток
ФНОα γИФ ИЛ-1 1. Усиление экспрессии АГ Клеточных мембран (ГКС, Fc) Активация фибробластов И эпителиальных клеток (непрофессиональные фагоциты) 2. Стимуляция ИЛ 1 и ИЛ 2 3. Активация фагоцитарной акт 4. Стимуляция выработки Ig 5. Индукция свободных радикалов
Медиаторы персистенции Chlamydia trachomatis Медиатор Эффект Низкие концентрации g -интерферона Резкое снижение количества эндогенного триптофана (активация фермента индоламин -2, 3 -диоксигеназы, расщепляющего триптофан до N-формилкинуренина) ФНО-a Дефицит эндогенного триптофана Опосредованный, путем активации b -ИФ (блокирует репродукцию внутриклеточных микроорганизмов, путем усиления экспрессии мембранных белков клеток) Необходим для построения МОМР Дефицит ц. ГМФ и высокое количество ц. АМФ Отсутствие активации ферментов необходимых для дифференциации РТ в ЭТ Дефицит и/или действие антагонистов Са 2+ Нарушение агрегации эндосомальных вакуолей
Медиаторы персистенции Chlamydia trachomatis (продолжение) L-изолейцин Эффект возможно обусловлен включением продукта метаболизма a -метилбутарила. Со. А в синтез жирных кислот С. trachomatis с последующим встраиванием «чужих» триглицеридов в клеточную мембрану, приводя к ее дестабилизации Дефицит цистеина Незаменима аминокислота, контролирующая дифференциацию РТ в ЭТ (включается в 3 важнейших для дифференциации белка), уменьшение числа дисульфидных мостиков факторов прочности клеточной стенки.
«Генетический дрейф» , или антигенная мимикрия: Аминокислотная последовательностиь 264 -286 главного сигма-фактора РНК-полимеразы хламидий (Chl. trachomatis). L 7 (пептид II), один из рибосомальных белков АТ Ревматические аутоиммунные заболевания
Персистенция Francisella tularensis цитохолазин-Внечувствительный путь Каспазы 3 и 9 TNF, IL 1 23 -k. Da эндосомы
+Антилизоцимная Антилактоферриновая Антикомплиментарная Активность ЛПС francisella tularentis S-ЛПС R-ЛПС Остаточная вирулентность вирулентные Низкая Чувствительность хозяина LPS-binding protein – LBP Инертный ЛПС Быстрая элиминация Высокая Чувствительность хозяина Гибель организма персистенция
Персистенция и адаптивный мутагенез в биопленках: Устойчивость биопленок к внешним воздействи ям характеризуют термином “персистенция” (от англ. persistence – выносливость, живучесть). Мертвые клетки
Значение персистенции в биопленках По данным Центра контроля заболеваний (CDC USA), около 65% всех инфекций обусловлено формированием в макроорганизме биопленок Образование биопленок на всех вводимых в макроорганизм медицинских устройствах (катеторы, протезы, стенты и тд); Образование биопленок на медицинском инструментарии…
бактерия + dna. J (синтез шаперона) у. E. coli pmr. C (синтез фосфолипидов) у. S. typhimurium Неблагоприятные условия Экспрессия SOS-генов Ген rmf, ингибитор трансляции Гены теплового и холодового шока rec. A, umu. DC, uvr. AB, sul. A Клетки-персистеры htr. A, htp. X, csp. H, clp. B, cbp. AB Гены системы «токсинантитоксин» din. J/yaf. Q, yef. M, rel. BE, maz. EF
Ген А Ген Т Ген Р антибиотик антитоксин рибосома Дефектный белок Нормальный белок Комплекс Т-А Нет синтеза белка персистенция
Основные токсины и место их приложения у E. Coli: токсин мишень активность Процесс Ccd B ДНК-гираза Двухцепочечные разрывы Репликация Rel E Транслирующие рибосомы Расщепление м. РНК Трансляция Maz F РНК Эндорибонуклеаза Трансляция Par E ДНК-гираза Двухцепочечные разрывы Репликация Doc Транслирующие рибосомы Расщепление м. РНК Трансляция Vap C РНК Эндорибонуклеаза Неизвестно Ξ-токсин Неизвестно Фосфотрансфераза Неизвестно Hip A EF-TU Протеинкиназа Трансляция Hip B Транслирующие рибосомы Расщепление м. РНК Трансляция
Сигма-фактор РНК-полимеразы Rpo. S Адаптивный мутагенез: ? “Адаптивными” называют мутации, которые возникают в медленно размножающейся или покоящейся популяции микроорганизма в период продолжительного стресса и которые противодействуют причинам, вызывающим данный стресс. Veillonella parvula Streptococcus mutans Устойчивость к антибиотикам
Lewis K. 2008 год считает, что главным способом борьбы с персистенцией в биопленках является «рассеянность пациентов» …
Полностью или частично утратившие клеточную стенку или предшественников ее биосинтеза, растущие в виде характерных мелких колоний. Впервые открыты в 1935 г. Клинебергер (E. Klieneberger) в культуре Streptobacillus moniliformis, выделенной К. Левадити с сотр. в 1932 г. из суставной жидкости больного эпидемической суставной эритемой. Streptobacillus moniliformis — грамотрицательная, гемоглобинофильная палочка с четковидными вздутиями на концах, хорошо растущая на кровяном (10-20%) агаре и свернутой сыворотке.
При изучении экспериментальной инфекции у крыс Клинебергер выделила несколько штаммов, содержащих, помимо типичных бактериальных форм, полиморфные микроорганизмы, весьма сходные по виду колоний и морфологии с плевропневмониеподобными организмами — pleuropneumoniae like organism (P PL О). Эти микроорганизмы были названы в честь Ин-та им. Листера — L-формой.
В течение многих лет Клинебергер рассматривала L-формы как представителей PPLO-симбионтов бактерий Streptobacillus moniliformis. Доказательством симбиотического существования двух разных микроорганизмов являлось отсутствие реверсии бактерий из L-форм на протяжении 13 лет (350 пересевов).
Разнообразные эксперименты амер. исследователя Дайнеса (L. Dienes) и др. доказали ошибочность концепции Клинебергер. Было показано, что L-формы Streptobacillus moniliformis, Fusiformis necrophorus и других бактерий способны реверсировать в исходный вид бактерий. Образование L-форм бактерий описано под названиями «L-трансформация», «L-конверсия», «индукция L-форм».
В. Д. Тимаковым и Г. Я. Каган были получены L-формы многих видов бактерий, изучены их биол, свойства и роль в патологии (ревмокардит, септический эндокардит, менингоэнцефалит, хрон, гонорея и др.).
Превращение в L-форму — свойство, по всей вероятности, присущее всем бактериям. Препараты, оказывающие L-трансформирующее действие, либо блокируют определенные звенья биосинтеза клеточных стенок, преимущественно пептидогликана (муреина), либо их разрушают. К препаратам, индуцирующим L-формы бактерий, относят: 1) антибиотики соответствующего спектра действия, напр, пенициллин, циклосерин, лизостафин и др.; 2) муролитические ферменты — лизоцим, эндоацетилгексозаминидазу фагоассоциированного лизина стрептококка группы С и др.; 3) нек-рые аминокислоты (глицин и др.).
Индукция L-форм бактерий зависит от условий и сред культивирования: необходимо создание физ.-хим. окружения, способствующего стабилизации осмотически хрупкой мембраны бактерий и предохраняющего L-формы от гибели.
Состав среды и условия культивирования варьируют в зависимости от вида бактерий, обязательны полутвердая и полужидкая концентрация агарового геля, присутствие нормальной лошадиной сыворотки и подбор осмотической концентрации солей, способствующих сохранению целостности цитоплазматической мембраны L-форм бактерий.
Различают нестабильные и стабильные L-формы бактерий. Нестабильные формы сохраняют нек-рые элементы клеточной стенки или ее предшественников и при пассажах на средах без L-индуцирующего агента реверсируют в исходный вид бактерий. Стабильные формы полностью утрачивают компоненты клеточной стенки и не способны ее восстановить, поэтому они не реверсируют в исходный вид бактерий, даже при многократном пассировании на средах без индуцирующего агента, а также на средах, содержащих сукцинат натрия или желатину, способствующих реверсии бактерий из L-форм.
L-формы бактерий растут в виде двух типов колоний — А. и В. Колонии типа А чаще присущи стабильным L-формам бактерий, они очень мелкие (50-100 мкм), врастают в агар, хорошо растут группами, единичные колонии часто не дают роста. Минимальные репродуцирующиеся элементы колоний типа А, полностью лишенные клеточной стенки, не имеют фаговосприимчивых рецепторов. Колонии типа В чаще присущи нестабильным L-формам бактерий, они более крупные, размером 0,5-2 мм, с нежным кружевным краем и врастающим в среду центром. В колониях преобладают шаровидные тела разной оптической плотности; субмикроскопических элементов в них меньше, чем в колониях типа А. Они сохраняют нек-рые элементы клеточной стенки, фаговосприимчивые рецепторы и могут агглютинироваться сывороткой исходного вида.
Дифференциация колоний на типы А и В условна, так же как и явление стабилизации L-форм. В культурах стабильных L-форм бактерий могут содержаться, колонии типа В, а в культурах нестабильных L-форм- колонии типа А.
В составе колоний L-форм бактерий содержатся: 1) сферические тела разной оптической плотности и размеров; 2) элементарные тельца или гранулы, располагающиеся группами, а также интрацеллюлярно в более крупных сферических образованиях или вакуолях; 3) плохо контурированные, бесформенные, все время растущие тела; 4) извитые формы; 5) крупные тела с включениями в виде вакуолей. L-формы бактерий отличаются полиморфизмом (рис. 1, 1-6) и вместе с тем принципиально одинаковы у разных видов бактерий/ что не позволяет дифференцировать их по морфол, признаку.
Наряду с утратой клеточной стенки у L-форм бактерий утрачиваются мезосомы, что приводит к непосредственному прикреплению цитоплазматической мембраны к нуклеоиду; восстановления мезосом в процессе реверсии не наблюдается.
Отсутствие клеточной стенки обусловливает дезорганизацию деления и множественность морфол, проявлений при воспроизведении L-форм бактерий. Размножаются L-формы бактерий делением, почкованием или дезинтеграцией клетки на мелкие гранулы.
Физиол., антигенные и патогенные особенности этих форм детерминированы структурой их цитоплазматической мембраны, и, возможно, цитоплазмы.
L-формы бактерий образуются не только in vitro, но и in vivo, они могут сохраняться в организме и реверсировать в исходную бактериальную форму.
На рисунке 2 приведены результаты получения L-форм S. typhi in vivo под влиянием пенициллина. Бактерии и антибиотик вводили одновременно интраперитонеально мышам. При введении 100 ЕД пенициллина на 1 г веса образовывались нестабильные L-формы, реверсирующие в исходные бактериальные формы через 24-48 час., к-рые вызывали гибель животных. При введении 2000 ЕД пенициллина на 1 г веса в течение 24-48 час. образовывались стабильные L-формы, подвергавшиеся фагоцитозу; гибели животных в ближайшие 5 сут. не наблюдалось. Аналогичные данные получены при изучении индукции in vivo L-форм других бактерий.
Разработана оригинальная схема выделения L-форм из патол, материала, к-рая позволила выделить и идентифицировать L-формы бактерий из цереброспинальной жидкости больных гнойным менингитом и ревмокардитом.
На рисунке 3 представлены микрофотографии L-форм, выделенных из крови больного ревмокардитом, и их ревертантов, образовавшихся в результате реверсии в стрептококки, впоследствии идентифицированные как Streptococcus hemolyticus группы А.
Антитела к стабильным L-формам Streptococcus hemolyticus обнаружены у 87,9% больных ревматизмом, у 77% больных инфекционно-аллергическим миокардитом и всего лишь у 11% здоровых людей (В. Д. Тимаков, Г. Я. Каган, 1973). L-формы разных видов бактерий обнаруживаются при хрон, бактериурии, пиелонефритах, абактериальных формах туберкулеза, ревмокардите и др.
Патогенность L-форм бактерий доказана экспериментально, известны хрон, артриты, вызванные интраартикулярным введением L-форм Streptococcus hemolyticus, ангина обезьян, осложненная интерстициальным миокардитом, индуцированная внутривенным введением L-форм Streptococcus hemolyticus, пиелонефриты крыс и кроликов, обусловленные L-формами бактерий рода Proteus и Streptococcus faecalis, менингоэнцефалит кроликов, связанный с L-формами менингококка, и листериоз овец и кроликов, вызванный введением L-форм Listeria monocytogenes. Патол, процессы, обусловленные L-формами бактерий, отличаются постепенным развитием патол. явлений, пролонгированным течением и персистенцией возбудителя в L-форме, поддерживающей переход заболевания в хрон, форму. Персистенция L-форм бактерий установлена экспериментально на L-формах Mycobacterium tuberculosis и Streptococcus hemolyticus.
При однократном внутрибрюшинном заражении белых мышей стабильными L-формами Streptococcus hemolyticus и последующем наблюдении в течение года антиген L-форм сохраняется во всех внутренних органах. На рисунке 4, 1 приведен пример локализации L-форм Streptococcus hemolyticus в селезенке через 3 нед. после инфицирования, на рисунке 4, 2 — через 27 нед. Длительная персистенция L-форм в организме сопровождается нарастанием повреждающего эффекта; развитием интерстициального миокардита и тяжелого гломерулонефрита.
Образование L-форм бактерий in vivo, их связь со многими хронически протекающими процессами, возможность реверсии бактериальных форм с восстановлением их вирулентности и возникновение вследствие этого не поддающихся эффективной терапии рецидивов поставили перед мед. микробиологией проблему изыскания способов борьбы с вариантами микроорганизмов, утратившими клеточную стенку (сферопласты, протопласты, L-формы). Поиски ведутся с двух диаметрально противоположных позиций: 1) предотвращение возможности индукции L-форм in vivo (путь, трудно контролируемый); 2) использование средств, индуцирующих образование L-форм, с последующим применением других препаратов, недейственных в отношении интактных клеток, но проникающих внутриклеточно лишь в L-формы бактерий и разрушающих их. Этот путь наиболее перспективный. Имеются данные об эффективности комбинаций пенициллина и канамицина, используемых для терапии пиелонефритов. Пенициллин индуцирует образование L-форм бактерий, к-рые разрушаются внутриклеточным проникновением канамицина, не действующего на интактные бактерии.
Библиогр.: Пешков М. А. Цитология бактерий, с. 151, М.-Л., 1955; Тимаков В.Д, и Каган Г. Я. L-формы бактерий и семейство mycoplasmataceae в патологии, М., 1973, библиогр.; они же, L-формы бактерий, семейство mycoplasmataceae и проблема микробного персистиро-вания, Журн, микр., эпид, и иммун., № 4, с. 3, 1977, библиогр.; Di enes L. The morphology of the Li of Klieneberger and its relationship to streptobacillus monoli-formis, J. Bact., v. 54, p. 231, 1947; D i e-nes L. a. Weinberger H. The L-forms of bacteria, Bact. Rev., v. 15, p. 245, 1951; Klieneberger E. The natural occurrence of pleuropneumonialike organisms, its apparent symbiosis with streptobacillus moniliformis and the other bacteria, J. Path. Bact., v. 40, p. 93, 1935; K li eneb erger-N obel E. Pleuropneumonia-like organisms (PPLO) mycoplasmataceae, L.- N. Y., 1962; Microbial protoplasts, spheroplasts and L-forms, ed. by L. B. Guze, Baltimore, 1968.
В. Д. Тимаков, Г. Я. Каган.
А. Г. Хоменко
Микобактерии туберкулеза
могут попадать в организм различными путями: аэрогенно, энтерально (через желудочно-кишечный тракт), через поврежденную кожу и слизистые оболочки, через плаценту при развитии плода. Однако основным путем заражения является аэрогенный.
Определенную защитную роль при аэрогенном заражении
играет система мукоциллиарного клиренса, позволяющая частично вывести попавшие в бронхи частицы пыли, капли слизи, слюны и мокроты, содержащие микроорганизмы. При энтеральном заражении определенное значение может иметь всасывающая функция кишечника.
Локальные изменения в месте внедрения микобактерий
обусловлены прежде всего реакцией полинуклеарных клеток, которая сменяется более совершенной формой защитной реакции с участием макрофагов, осуществляющих фагоцитоз и разрушение микобактерий. Процесс взаимодействия легочных макрофагов с различными микроорганизмами, в том числе микобактериями туберкулеза, сложен и до конца не изучен. Результат взаимодействия макрофагов и микобактерий определяется состоянием иммунитета, уровнем ПЧЗТ, развивающейся в процессе туберкулезной инфекции, а также рядом других факторов, в том числе обусловливающих переваривающую способность макрофагов.
Фагоцитоз
состоит из трех фаз: фазы соприкосновения, когда макрофаги с помощью рецепторов на клеточной мембране фиксируют микобактерии; фазы проникновения микобактерий внутрь макрофага путем инвагинации стенки макрофага и «окутывания» микробактерии; фазы переваривания, когда лизосомы макрофагов сливаются с фагосомами, содержащими микобактерии. Выделяющиеся в фа гол изосомы ферменты разрушают микобактерии. В процессе фагоцитоза важная роль принадлежит также механизмам перекисного окисления .
Микобактерии туберкулеза, как и некоторые другие микроорганизмы, попадая в макрофаги, могут сохраняться и даже продолжать размножение. В тех случаях, когда процесс переваривания микобактерий блокируется, происходят разрушение макрофагов и выход микобактерий из поглотивших их клеток.
Макрофаги, фагоцитировавшие микобактерии и осуществляющие их переваривание, выделяют во внеклеточное пространство фрагменты разрушенных микобактерий, протеолитических ферменты, медиаторы (в том числе интерлейкин-1), которые активируют Т- лимфоциты, в частности Т-хелперы.
Активированные Т-хелперы выделяют медиаторы — лимфокины (в том числе интерлейкин-2), под влиянием которых происходит миграция новых макрофагов к месту локализации микобактерий. Одновременно подавляется синтез фактора угнетения миграции, возрастает ферментативная активность макрофагов под влиянием фактора активации макрофагов. Активированные лимфоциты выделяют также кожно-реактивный фактор, который обусловливает воспалительную реакцию, повышение сосудистой проницаемости. С этим фактором связывают подавление ПЧЗТ и положительной туберкулиновой реакции [Медуницын Н. В. и др., 1980]. Кроме Т-хелперов, на состояние иммунитета значительно влияют Т-супрессоры и супрессорные моноциты, которые угнетают иммунный ответ.
Помимо Т-лимфоцитов и макрофагов, важная роль в патогенезе туберкулезного процесса принадлежит веществам, освобождающимся при разрушении микобактерий. Эти вещества (фракции) подробно изучены . Доказано, что корд-фактор (фактор вирулентности микобактерий туберкулеза, обусловливающий их рост на плотной питательной среде в виде «кос»), провоцирует острый воспалительный процесс, а сульфатиды повышают токсичность корд-фактора и, главное, подавляют образование фаголизосом в макрофагах, что предохраняет внутриклеточно расположенные микобактерии от разрушения.
При интенсивном размножении микобактерий
в организме человека вследствие малоэффективного фагоцитоза выделяется большое число токсичных веществ, индуцируется резко выраженная ПЧЗТ, которая способствует появлению экссудативного компонента воспаления с развитием казеозного некроза и его размножения. В этот период увеличивается число Т-супрессоров, снижается число Т-хелперов, что приводит к угнетению ПЧЗТ. Это обусловливает прогрессирование туберкулезного процесса.
При сравнительно небольшой бактериальной популяции
в условиях ПЧЗТ и эффективного фагоцитоза отмечается образование туберкулезных гранулем. Такая гранулема развивается в результате реакций ПЧЗТ [Авербах М. М. и др., 1974]. Скопление мононуклееров вокруг нейтрофилов, содержащих антиген, и их последующая трансформация происходят под регулирующим влиянием лимфокинов, вырабатываемых Т-лимфоцитами (в частности, Т-хелперами) и являющихся медиаторами гранулематозной реакции. Поскольку величина бактериальной популяции, а также характер течения иммунологических ракций на разных этапах туберкулезной инфекции меняются, морфологические реакции у заболевших туберкулезом характеризуются большим разнообразием.
В зависимости от места внедрения микобактерий туберкулеза
воспалительный очаг, или первичный аффект, может образоваться в легких, ротовой полости, миндалинах, кишечнике и др. В ответ на образование первичного аффекта развивается специфический процесс в регионарных лимфатических узлах и формируется первичный туберкулезный комплекс. Установлено, что первичный туберкулез, развивающийся в результате первого контакта макроорганизма с возбудителем, может проявляться не только в виде первичного туберкулезного комплекса, как это считалось ранее. В результате первичного заражения возможно развитие туберкулеза внутригрудных лимфатических узлов, плеврита, туберкулемы, очагового процесса.
Первичный туберкулез в результате «свежего» заражения развивается лишь у 7-10% инфицированных лиц, остальные переносят первичную туберкулезную инфекцию без клинических проявлений. Наступившее заражение проявляется лишь в изменении туберкулиновых реакций.
Еще В. И. Пузик (1946), А. И. Каграманов (1954) и др. установили, что формированию первичного комплекса нередко предшествует период «латентного микробизма», при котором микобактерии туберкулеза, попадая в организм, какое-то время находятся в нем, не вызывая воспалительной реакции. При этом микобактерии чаще обнаруживаются в лимфатических узлах, особенно внутригрудных. В этих случаях локальные изменения в легких или других органах в виде очагов первичного туберкулеза возникают в поздний период первичной инфекции и не в месте проникновения микобактерий в организме, а в участках, наиболее благоприятных для развития туберкулезного воспаления.
Отсутствие клинико-морфологических проявлений первичной туберкулезной инфекции может быть объяснено высоким уровнем естественной резистентности к туберкулезу, а также может быть следствием приобретенного в результате вакцинации БЦЖ иммунитета.
При наличии локальных проявлений первичный туберкулез может протекать с развитием распространенного процесса по осложненному типу или, что в настоящее время наблюдается значительно чаще, по неосложненному типу с ограниченной воспалительной реакцией.
Как правило, первичный туберкулез заживает с небольшими остаточными изменениями, что, по-видимому, связано с высокой естественной резистентностью и проведением массовой вакцинации и ревакцинации БЦЖ.
Сохраняющиеся в остаточных очагах микобактерии или их измененные формы должны рассматриваться как туберкулезный антиген, наличие которого необходимо для поддержания сенсибилизированными лимфоцитами специфического иммунитета. Определенная, правда, еще малоизученная роль в поддержании противотуберкулезного иммунитета принадлежит В-клеточному иммунитету и генетическим механизмам.
Получены доказательства роли наследственности в течение туберкулезного процесса
. Генетические факторы влияют на ответ иммунной системы при размножении микобактерий туберкулеза в организме человека и, в частности, определяют взаимодействие между макрофагами, Т- и В-лимфоцитами, продукцию лимфокинов, монокинов и других цитокинов Т- и В-лимфоцитами и макрофагами, комплексный иммунный ответ, от которого зависит чувствительность или устойчивость к развитию туберкулеза. Выявлено сцепление HLA-генотипов с заболеванием туберкулезом в семьях, в которых больны туберкулезом родители и дети.
Накопление некоторых специфичных типов HLA в группах больных с неблагоприятным течением болезни свидетельствует об ассоциации определенных генов HLA-комплекса (преимущественно локусов В и DR с предрасположенностью к туберкулезу) [Хоменко А. Г., 1985].
Период первичного инфицирования может завершиться излечением с минимальными (малыми) или довольно выраженными остаточными изменениями. У таких людей развивается приобретенный иммунитет. Сохранение в остаточных очагах персистирующих микобактерий не только поддерживает приобретенный иммунитет, но и одновременно создает риск эндогенной реактивации туберкулезного процесса вследствие реверсии измененных форм возбудителя туберкулеза в бактериальную форму и размножения микобактериальной популяции.
Реверсия персистирующих форм микобактерий в размножающиеся происходит в условиях эндогенной реактивации туберкулезных очагов и других остаточных изменений. Механизм эндогенной реактивации, а также развитие туберкулезного процесса изучены недостаточно.
В основе реактивации
лежат прогрессирующее размножение бактериальной популяции и увеличение количества микобактерий [Хоменко А. Г., 1986]. Однако до настоящего времени остается неизвестным, что именно и какие условия способствуют реверсии возбудителя туберкулеза, находившегося в персистирующем состоянии. Установлено, что реактивация туберкулеза и развитие различных его клинических форм чаще наблюдаются у лиц с остаточными изменениями при наличии факторов, снижающих иммунитет.
Возможен и другой путь развития вторичного туберкулеза
— экзогенный, связанный с новым (повторным) заражением микробактериями туберкулеза (суперинфекция). Но и при экзогенном пути развития вторичного туберкулеза недостаточно проникновения микобактерий в уже инфицированный организм даже при массивной повторной суперинфекции. Необходима совокупность ряда условий и факторов риска, снижающих иммунитет. Вторичный туберкулез характеризуется большим разнообразием клинических форм.
Основные разновидности патоморфологических изменений
в легких и других органах характеризуются:
- очагами с преимущественно продуктивной тканевой реакцией, благоприятным, хроническим течением и тенденцией к заживлению;
- инфильтративно-пневмоническими изменениями с преимущественно экссудативной тканевой реакцией и тенденцией к развитию казеозного некроза или рассасыванию возникшей воспалительной реакции;
- туберкулезной каверной — результатом разложения образовавшихся казеозных масс и их отторжения через дренажные бронхи с образованием полости распада.
Различные сочетания основных патоморфологических изменений туберкулеза создают предпосылки для чрезвычайно большого разнообразия туберкулезных изменений, особенно при хроническом течении болезни со сменой периодов обострения и затихания процесса. К этому нужно добавить, что из сформировавшихся зон поражения микобактерии могут распространяться с током лимфы или крови в непораженные участки и различные органы. Исход болезни зависит от ее течения — прогрессирующего или регрессирующего, эффективности лечения и обратимости изменений, сформировавшихся в процессе болезни.
Доказано, что в условиях голодания и даже при недостаточном питании, особенно когда в рационе недостаточное количество белков и витаминов, нередко возникает реактивация туберкулеза. К факторам, способствующим реактивации
, относятся и различные заболевания: сахарный диабет, лимфогранулематоз, силикоз, язвенная болезнь желудка и двенадцатиперстной кишки, состояние после резекции желудка и двенадцатиперстной кишки, хронические воспалительные заболевания легких, психические заболевания, протекающие с депрессивным синдромом, алкоголизм, стрессовые ситуации, СПИД, длительный прием глюкокортикоидов, цитостатиков и иммунодепрессантов.
Течение и исходы туберкулеза
следует рассматривать только в условиях проводящейся специфической химиотерапии, которая применяется всем больным активным туберкулезом. В процессе химиотерапии отмечается уменьшение популяции микобактерий вследствие разрушающего влияния химиопрепаратов на возбудителей туберкулеза. Вследствие этого резко снижается число микобактерий, создаются более благоприятные условия для репара тивных процессов и саногенеза.
Вместе с тем при применении самых эффективных комбинаций современных химиопрепаратов отмечается разное течение туберкулезного процесса: регрессия с последующим заживлением, стабилизация процесса без клинического излечения с сохранением каверны, туберкулемы или других изменений, временное затихание воспалительного процесса с последующим возникновением обострения, развитием хронического процесса или прогрессированием заболевания.
Таким образом, уменьшение популяции микобактерий под влиянием специфических химиопрепаратов далеко не всегда приводит к излечению. Прекращение туберкулезного процесса и последующее излечение зависят не только от уменьшения популяции микобактерий, но и от способности репаративных процессов организма обеспечить регрессию туберкулезного процесса и его прекращение. Туберкулезное воспаление
Патоморфологические изменения в органах и тканях при туберкулезе многообразны и зависят от формы, стадии, локализации и распространенности патологического процесса.
Общими для большинства форм туберкулеза
являются специфические изменения в сочетании с неспецифическими или параспецифическими реакциями. К специфическим изменениям относится туберкулезное воспаление, течение которого сопровождается формированием туберкулезного бугорка, или гранулемы, и более крупного очага. Неспецифическими изменениями являются различные реакции, обусловливающие так называемые маски туберкулеза.
Морфология туберкулезного воспаления
зависит от реактивности организма и вирулентности возбудителя. В туберкулезном очаге могут преобладать явления экссудации, некроза или пролиферации, и очаг в соответствии с этим может быть преимущественно экссудативным, невротическим или продуктивным. В развитии туберкулезного воспаления большая роль принадлежит иммунологическим процессам.
В участке воспаления сначала развивается реакция, не имеющая признаков, типичных для туберкулеза. В ней в разной степени выражены явления альтерации и экссудации. На первое место выступают нарушения в микроциркуляторном русле. Они затрагивают тонкую структуру стенки альвеолы, и механизмы их развития можно проследить на ультраструктурном уровне [Ерохин В. В., 1987]. На ранних стадиях воспаления изменения в субмикроскопической организации составных элементов стенки альвеолы связаны с повышением капиллярной проницаемости, развитием внутриклеточного интерстициального и внутриальвеолярного отека с вымыванием отечной жидкостью альвеолярного сурфактанта.
В дальнейшем дистрофические изменения в альвеолярной ткани нарастают, однако наряду с ними возникают и компенсаторно-восстановительные процессы, направленные на развитие внутриклеточной организации, повышение функциональной активности сохраняющихся клеток межальвеолярной перегородки. В следующей фазе воспаления — пролиферативной — появляются специфические для туберкулеза элементы (эпителиоидные и гигантские клетки Пирогова-Лангханса), формируются участки своеобразного гомогенного казеозного (творожистого) некроза в центре туберкулезного очага.
На основании данных электронной микроскопии и авторадиографии о динамике клеточной трансформации установлена генетическая связь клеток гранулемы по линии моноцит — гигантская клетка [Серов В. В., Шехтер А. Б., 1981; Ерохин В. В., 1978, 1987; Danneberg А. М., 1982; SpectorW-G., 1982]. Макрофаги активно синтезируют и накапливают лизосомные ферменты, выполняют фагоцитарную функцию. Поглощенный материал, среди которого находятся и микобактерии туберкулеза, находится и переваривается в фагосомах и фаголизосомах.
Эпителиоидные клетки образуются из мононуклеаров и макрофагов, скапливающихся в очаге туберкулезного воспаления в первые фазы воспалительной реакции. Они имеют крупное ядро овальной формы, обычно с 1-2 ядрышками. Цитоплазма этих клеток содержит митохондрии, гранулы, аппарат Гольджи, хорошо развитую систему канальцев и цистерны зернистой и незернистой цитоплазматической сети, единичные фагосомы небольших размеров. Число митохондрий, элементов ретикулума, лизосомных включений широко варьирует и определяется функциональным состоянием клетки.
Гигантские клетки Пирогова-Лангханса могут образовываться из эпителиоидных клеток или макрофагов при их пролиферации, а также в результате слияния эпителиоидных клеток. Цитоплазма гигантских клеток содержит большое число ядер, обычно располагающихся в виде кольца или подковы по периферии клеток, множество митохондрий, лизосом, элементов зернистой цитоплазматической сети, хорошо развитый комплекс Гольджи. Гигантские клетки способны к фагоцитозу, в их цитоплазме обнаруживаются различные остаточные включения Они характеризуются высокой активностью гидролитических и дыхательных ферментов.
Помимо эпителиоидных и гигантских клеток, туберкулезная грануляционная ткань обычно содержит значительное число лимфоидные и плазматических клеток, а также нейтрофильный лейкоцитов. В периферических отделах грануляционного слоя выявляются фибробласты. Вокруг очага воспаления нередко имеется перифокальная зона неспецифической воспалительной реакции. При прогрессирования процесса наблюдаются увеличение казеозного некроза, усиление инфильтрации грануляционной ткани мононуклеарами и лимфоидными клетками, а также нейтрофилами, расширение зоны перифокального воспаления. Специфический процесс распространяется контактным и лимфатическим путем.
При заживлении туберкулезного очага массы казеозного некроза уплотняются, в последних отмечается отложение мелких зерен солей кальция. В грануляционной ткани увеличивается количество фибробластов и фибрилл коллагена, объединяющихся в коллагеновые волокна, которые вокруг туберкулезного очага формируют соединительнотканную капсулу. В последующем специфическая грануляционная ткань все больше замещается фиброзной тканью. Число клеточных элементов между коллагеновыми волокнами уменьшается, иногда коллагеновые волокна подвергаются гиалинозу.
В подобных очагах и посттуберкулезных очагах обнаружены измененные формы микобактерий туберкулеза, в частности L-формы, что позволяет лучше понять роль старых туберкулезных очагов в патогенезе вторичных форм туберкулеза [Пузик В. И., Земскова 3. С., Дорожкова И. Р., 1981, 1984]. В основе реактивации туберкулеза и формирования различных форм вторичного туберкулеза легких лежат реверсия и размножение бактериальной популяции на фоне развития недостаточности специфической и неспецифической защиты микроорганизма.
Неспецифические или параспецифические реакции могут формироваться в различных органах и тканях: нервной и сердечно-сосудистой системе, кроветворных органах, суставах, серозных оболочках и др. В сердечно-сосудистой системе и паренхиматозных органах указанные реакции проявляются очаговой или диффузной гистиоцитарной и лимфоцитарной инфильтрацией, в лимфатических узлах — пролиферацией ретикулярных и эндотелиальных клеток, в легких — образованием лимфоидных узелков. А. И. Струков (1959) считает, что эти реакции имеют токсико-аллергическую природу.
В. И. Пузик (1946) расценивает их как результат действия микобактерий туберкулеза в ранние периоды развития инфекционного процесса. Показана связь данных реакций с клеточным и гуморальным иммунитетом [Авербах М. М., 1976].
Благодаря профилактическим противотуберкулезным мероприятиям и специфическому лечению наблюдается значительный патоморфоз туберкулеза
. К истинному патоморфозу относят уменьшение числа казеозных пневмоний (что свидетельствует о повышении иммунитета), более частое образование туберкулем. Реже стали встречаться формы милиарного туберкулеза и туберкулезного менингита (особенно у детей).
Проявлениями индуцированного патоморфоза, обусловленного специфическим лечением, являются изолированные каверны, вокруг которых быстро рассасывается перифокальное воспаление, полное рассасывание или развитие мелких звездчатых рубчиков при гематогенно-диссеминированном туберкулезе, отторжение казеозно-некротических масс с формированием на месте каверны кистоподобной полости при фиброзно-кавернозном туберкулезе.
Применение наиболее эффективных химиопрепаратов приводит к полному излечению от туберкулеза. Чаще наблюдается разное течение туберкулезного воспаления: стабилизация и обратное развитие, приобретение хронического характера с периодами затихания и обострения специфического процесса. Решающее значение принадлежит макроорганизму, состоянию его защитных механизмов, способности противостоять действию антигенного раздражителя, а также развитию полноценных репаративных процессов.
Клинико-морфологические проявления первичного инфицирования микобактериями туберкулеза принято называть первичным туберкулезом. Первичный туберкулез
развивается лишь у 7-10% инфицированных лиц, чаще детей, у остальных же заражение проявляется лишь виражом туберкулиновых проб [Хоменко А. Г., 1989]. Отсутствие клинических проявлений первичного заражения объясняется высоким уровнем неспецифической и специфической резистентности к туберкулезу, развившейся в результате противотуберкулезной вакцинации БЦЖ.
Организм справляется с туберкулезной инфекцией, пройдя период возникновения «малых» неспецифических и специфических реакций. В результате организм приобретает иммунитет к туберкулезу и болезнь не развивается. В настоящее время реже, чем раньше, наблюдается хроническое течение первичной туберкулезной инфекции в виде разнообразных параспецифических реакций, или «масок туберкулеза».
Наиболее частой формой первичного туберкулеза является бронхоаденит, нередко протекающий без казеинфикации лимфатических узлов и формирования очагов в легких. При снижении сопротивляемости организма и более массивного инфицирования в лимфатических узлах развивается специфическое воспаление с образованием очагов творожистого некроза. Изменения распространяются на капсулу и прилежащие участки легкого, при этом формируется прикорневой инфильтрат, как правило, неспецифической природы. Процесс может переходить на стенки бронхов с образованием микрофистул.
При заживлении в лимфатических узлах наблюдаются рассасывание перифокального воспаления, уплотнение казеоза, отложение солей кальция в казеозе, нарастание фиброзных изменений в капсуле и окружающей прикорневой области.
Первичный туберкулез может проявляться формированием в легком первичного туберкулезного очага. Этот очаг имеет пневмонический характер с казеозом в центре и широкой перифокальной зоной воспаления снаружи. Вслед за формированием легочного аффекта отмечается поражение регионарных лимфатических узлов с «дорожкой» из измененных лимфатических сосудов между ними. Это соответствует картине первичного комплекса с его тремя составными компонентами.
При заживлении перифокальное воспаление рассасывается, казеоз в очаге уплотняется, откладываются соли кальция, а вокруг очага формируется соединительнотканная капсула. Может произойти полное замещение казеозного очага фиброзом. В лимфатических узлах преобладают процессы инкапсуляции и обызвествления казеозных масс.
В случае прогрессирования первичного комплекса пневмонический фокус увеличивается в размерах, подвергается казеинфикации с формированием острых пневмониогенных каверн. Вокруг каверны затем формируется соединительнотканная капсула, и процесс переходит в фиброзно-кавернозный туберкулез.
Прогрессирующее течение первичного туберкулеза может проявиться в виде милиарного туберкулеза в результате «прорыва» инфекции в кровеносное русло. Важно помнить о возможности острой диссеминации инфекции; необходимо своевременно диагностировать подобные случаи, так как рано начатое лечение дает хороший эффект.
Следовательно, периоду первичного заражения наряду с распространением инфекции по лимфатическим путям присущи и гематогенные отсевы, характеризующие бациллемию с возникновением очагов специфического воспаления в различных органах и тканях. Очаги-отсевы в легких, формирующиеся в различные периоды первичного туберкулеза, нередко являются случайной находкой при рентгеноанатомическом обследовании людей, не страдающих активными формами туберкулеза.
Такие очаги состоят из казеоза, окруженного фиброзной капсулой, бедной клеточными элементами. Очаги, как правило, множественные, располагаются в верхних сегментах легких под плеврой. С обострения процесса в этих очагах начинается вторичный туберкулез, характеризующийся локальным поражением органа. Таким образом, послепервичным очагам принадлежит большое значение в патогенезе вторичного туберкулеза.
Накоплен экспериментальный материал, демонстрирующий способность НФ возобновлять рост в благоприятных условиях. Условия реверсии включают использование различных индукторов реверсии (физических, химических, биотических), но могут заключаться и только в отмене неблагоприятных воздействий, как, например, показано для микроорганизмов, подвергнутых воздействию гамма-лучей.
Среди физических факторов наиболее часто к реверсии приводит повышение температуры с 0,5-6оС до 20-22о С или до 37оС, кратковременный прогрев до 45оС. Быстрое увеличение КОЕ в микрокосмах рассматривается как подтверждение реверсии, а не возобновление роста нескольких выживших клеток.
В ряде случаев оптимизацией температуры не удается стимулировать реверсию. V. parahaemolyticus реверсирует при повышении температуры до 25оС в сочетании с использованием минимальной солевой среды. НФ V. harveyi and V. fischeri возобновляют рост при добавлении органических или неорганических источников азота, углерода или деструкторов перекиси водорода.
Среди химических индукторов реверсии НФ известна группа соединений, разрушающих перекись водорода (антиоксиданты). К таким соединениям относят пируват натрия, каталазу, витамин Е. Их вводят непосредственно в микрокосмы в качестве протекторов или в состав питательных сред, предназначенных для реверсии. Это позволило получить реверсию E. coli, V. parahaemolyticus. На эффективность реверсии влияет химический состав среды и ее агрегатное состояние (предпочтительнее жидкие питательные среды).
Для реверсии НФ в питательные среды добавляют ростовые биотические факторы: фетальную сыворотку, супернатант растущей культуры или выделенный из нее рекомбинантный белок Rpf. Сообщается о влиянии цитокинов на реверсию НФ. Некультивируемые вирулентные штаммы сальмонелл реверсировали in vitro и in vivo в присутствии фактора некроза опухоли (ФНО) .
Иногда единственно эффективный способ реверсии — это пассаж через восприимчивый организм. Так, например, рекультивация НФ патогенных штаммов сальмонелл при введении в организм чувствительных животных всегда приводила к положительному результату. Параллельная рекультивация тех же суспензий in vitro не давала положительных результатов .
Истинность реверсии, а не возобновление роста выживших клеток, остается наиболее дискуссионным вопросом. В качестве доказательства реверсии используют рост из небольшого инокулюма. Рост культуры из маленького количества у вегетативных клеток происходит гораздо медленнее, чем в вариантах с НФ .
Клеточные структуры точно не изучались, поскольку сами клетки не культивировались, а известны исключительно по фрагментам ДНК. Видимо, все-таки придется выделять «некультивируемых» в чистые культуры. Однако для этого нужны дешевые, быстрые и доступные любой лаборатории методы генетического анализа. Тогда, например, обнаружив в образце ДНК «некультивируемых», можно начать подбирать среды и условия, каждый раз проверяя генетическими методами: выросшая колония — это искомый «некультивируемый микроорганизм», или нет? Если нет — опять варьировать среды и условия, пока, наконец «некультивируемый» не станет культивироваться. Другой возможный способ «взглянуть им в лицо» — это попробовать посадить на выделенную «некультивируемую» ДНК какую-нибудь флуоресцентную или радиоактивную метку, запустить в природу и посмотреть, с кем она сгибридизируется по принципу комплиментарности. Что же касается организации ДНК — в основном для диагностики используют не всю ДНК, а только участок, кодирующий 16S рибосомальную РНК, и здесь каких либо принципиальных отличий между бактериями, археями и «некультивируемыми», нет. 16S РНК выбрана по ряду вполне биологически обоснованных причин. Но такой подход еще и «от бедности»: анализировать целую ДНК очень накладно и трудоемко, полное секвенирование генома выполнено для очень немногих прокариот (вспомните, сколько сил и лабораторий по всему миру было задействовано на геном человека, а ведь у бактерии всего в 10 раз меньше генов, чем у нас) .